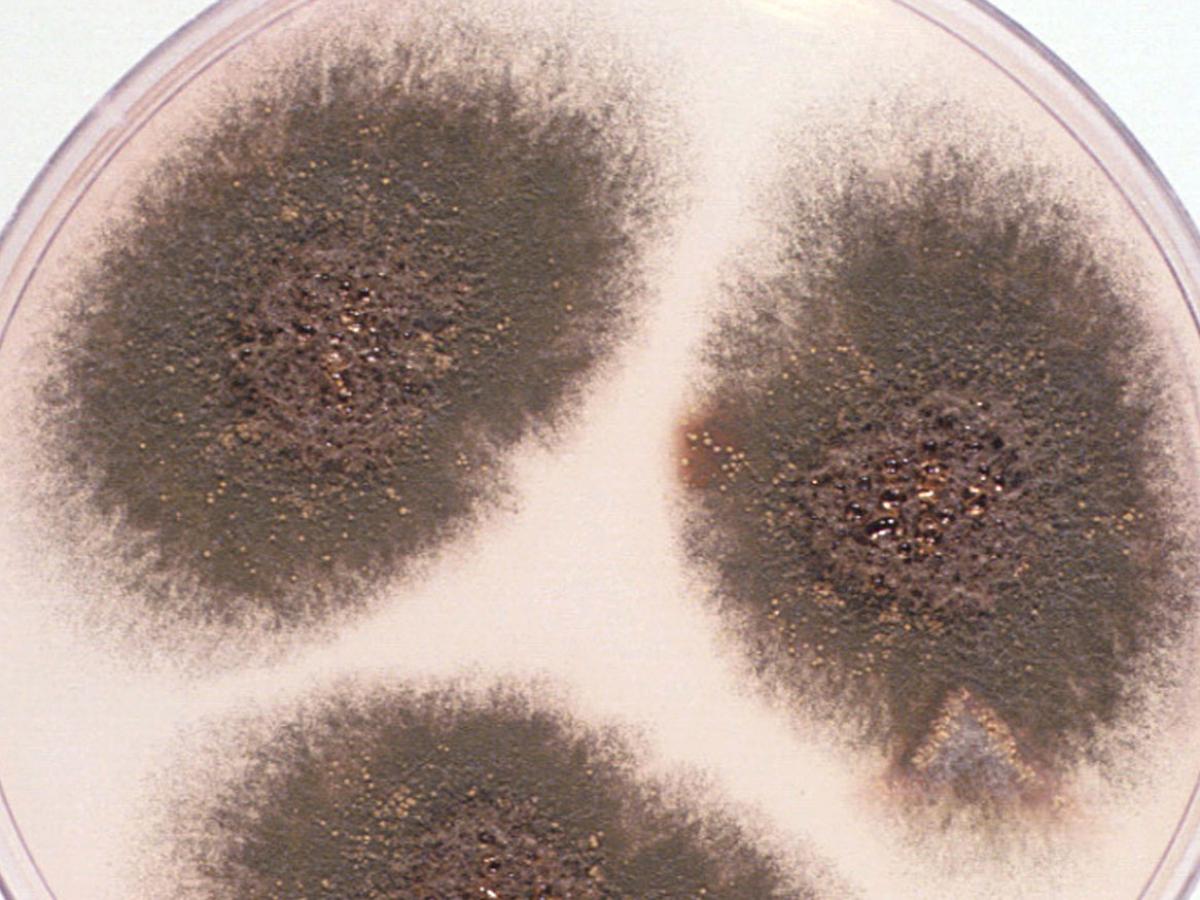
Unknown 29 culture

Unknown 29
Mould identification: a virtual self assessment
Case history
A 6 year old boy with chronic granulomatous disease presented with chronic pulmonary infiltrates. A needle biopsy showed the presence of hyphal elements on a Grocott’s methenamine silver (GMS) stained tissue section and the culture shown below was grown.

Direct microscopy (GMS)
Culture

Microscopy

Microscopy

Microscopy